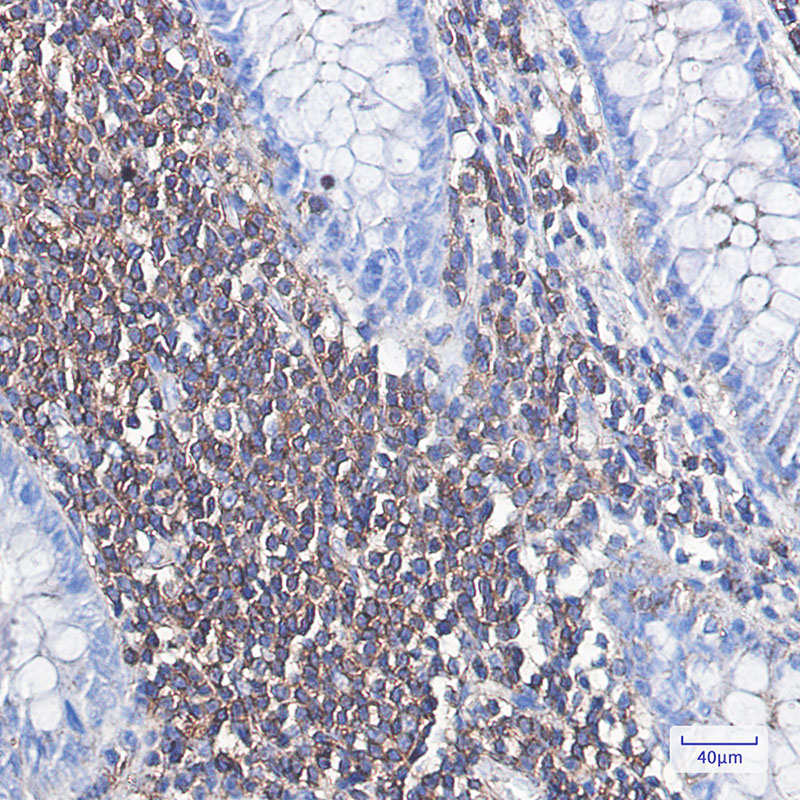

Product Name :
alpha Skeletal Muscle Actin monoclonal antibody Background :
Actins are highly conserved proteins that are involved in various types of cell motility and are ubiquitously expressed in all eukaryotic cells. Product :
50mM Tris-Glycine(pH 7.4), 0.15M NaCl, 40% Glycerol, 0.01% Sodium azide and 0.05% BSA Storage&Stability :
Store at 4°C short term. Aliquot and store at -20°C long term. Avoid freeze-thaw cycles. Specificity :
IgG Immunogen :
A synthetic peptide of human Actin Conjugate :
Unconjugated Modification :
Unmodified
alpha Skeletal Muscle Actin monoclonal antibody Background :
Actins are highly conserved proteins that are involved in various types of cell motility and are ubiquitously expressed in all eukaryotic cells. Product :
50mM Tris-Glycine(pH 7.4), 0.15M NaCl, 40% Glycerol, 0.01% Sodium azide and 0.05% BSA Storage&Stability :
Store at 4°C short term. Aliquot and store at -20°C long term. Avoid freeze-thaw cycles. Specificity :
IgG Immunogen :
A synthetic peptide of human Actin Conjugate :
Unconjugated Modification :
Unmodified
-
 Western blot analysis of Actin in HeLa lysates using alpha Skeletal Muscle Actin antibody.
Western blot analysis of Actin in HeLa lysates using alpha Skeletal Muscle Actin antibody. -
Western blot analysis of Actin in Jurkat, Ramos, MCF-7 lysates using Actin antibody.
Western blot analysis of Actin in Jurkat, Ramos, MCF-7 lysates using Actin antibody. -
 Western blot analysis of Actin in Jurkat, Ramos, MCF-7 lysates using Actin antibody.
Western blot analysis of Actin in Jurkat, Ramos, MCF-7 lysates using Actin antibody.
Bioworld Biotech only provide peptides for our antibodies and do not provide additional peptide customization services.
Price/Size :
USD 368/1mg/vial
Tips:
For phospho antibody, we provide phospho peptide(0.5mg) and non-phospho peptide(0.5mg).Describe :
Blocking peptides are peptides that bind specifically to the target antibody and block antibody binding. These peptide usually contains the epitope recognized by the antibody. Antibodies bound to the blocking peptide no longer bind to the epitope on the target protein. This mechanism is useful when non-specific binding is an issue, for example, in Western blotting (WB) and Immunohistochemistry (IHC). By comparing the staining from the blocked antibody versus the antibody alone, one can see which staining is specific; Specific binding will be absent from the western blot or IHC performed with the neutralized antibody.Formula:
Synthetic peptide was lyophilized with 100% acetonitrile and is supplied as a powder. Reconstitute with 0.1 ml DI water for a final concentration of 10 mg/ml.The purity is >90%,tested by HPLC and MS.
Storage:
The freeze-dried powder is more stable. For short time at 2-8°C. For long term storage store at -20°C.
Note :
This product is for research use only (RUO only). Not for use in diagnostic or therapeutic procedures.
 alpha Skeletal Muscle Actin monoclonal antibody
alpha Skeletal Muscle Actin monoclonal antibody  Datasheet
Datasheet COA
COA MSDS
MSDS SHIP
SHIP